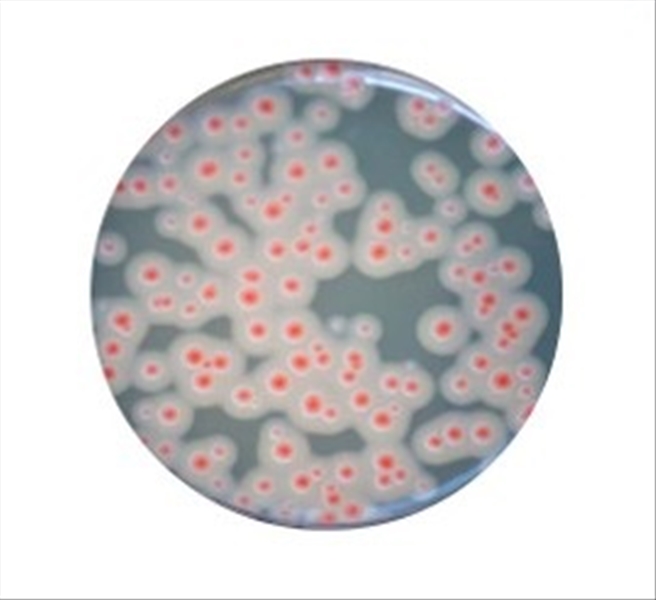

BACILLUS CEREUS CHROMOGENIC 20 PZ
- Disponibilidad limitada
- Código: L020351
Usuario NO autorizado a proceder con la cotización.
Área reservada Añadir a favoritos
Usuario NO autorizado a proceder con la cotización.
Área reservada Añadir a favoritos